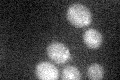
YHL019C
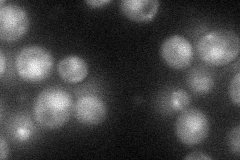
YHL019C

View description
Protein of unknown function, homologous to the medium chain of mammalian clathrin-associated protein complex; involved in vesicular transport
Localization:
Intensity:
Fold change:
Significance:
-
C’ GFP library in SD
punctate17.8 -
N' NOP1pr-GFP in SD
vacuole39.2134 -
N' TEF2pr-mCherry in SD

nucleus48.5226 -
N' NATIVEpr-GFP in SD

below threshold18.2289 -
N' TEF2pr-VC and Cyto-VN in SD

cytosol29.1453 -
C’ GFP library in SD+DTT

punctate18.281.02No -
C’ GFP library in SD+H2O2

punctate19.651.1No -
C’ GFP library in Starvation Media

punctate22.51.26No -
C’ GFP library on the background of Pup2-DaMP

punctate -
C’ GFP library on the background of CCT mutant

punctate15.85660.890198No
